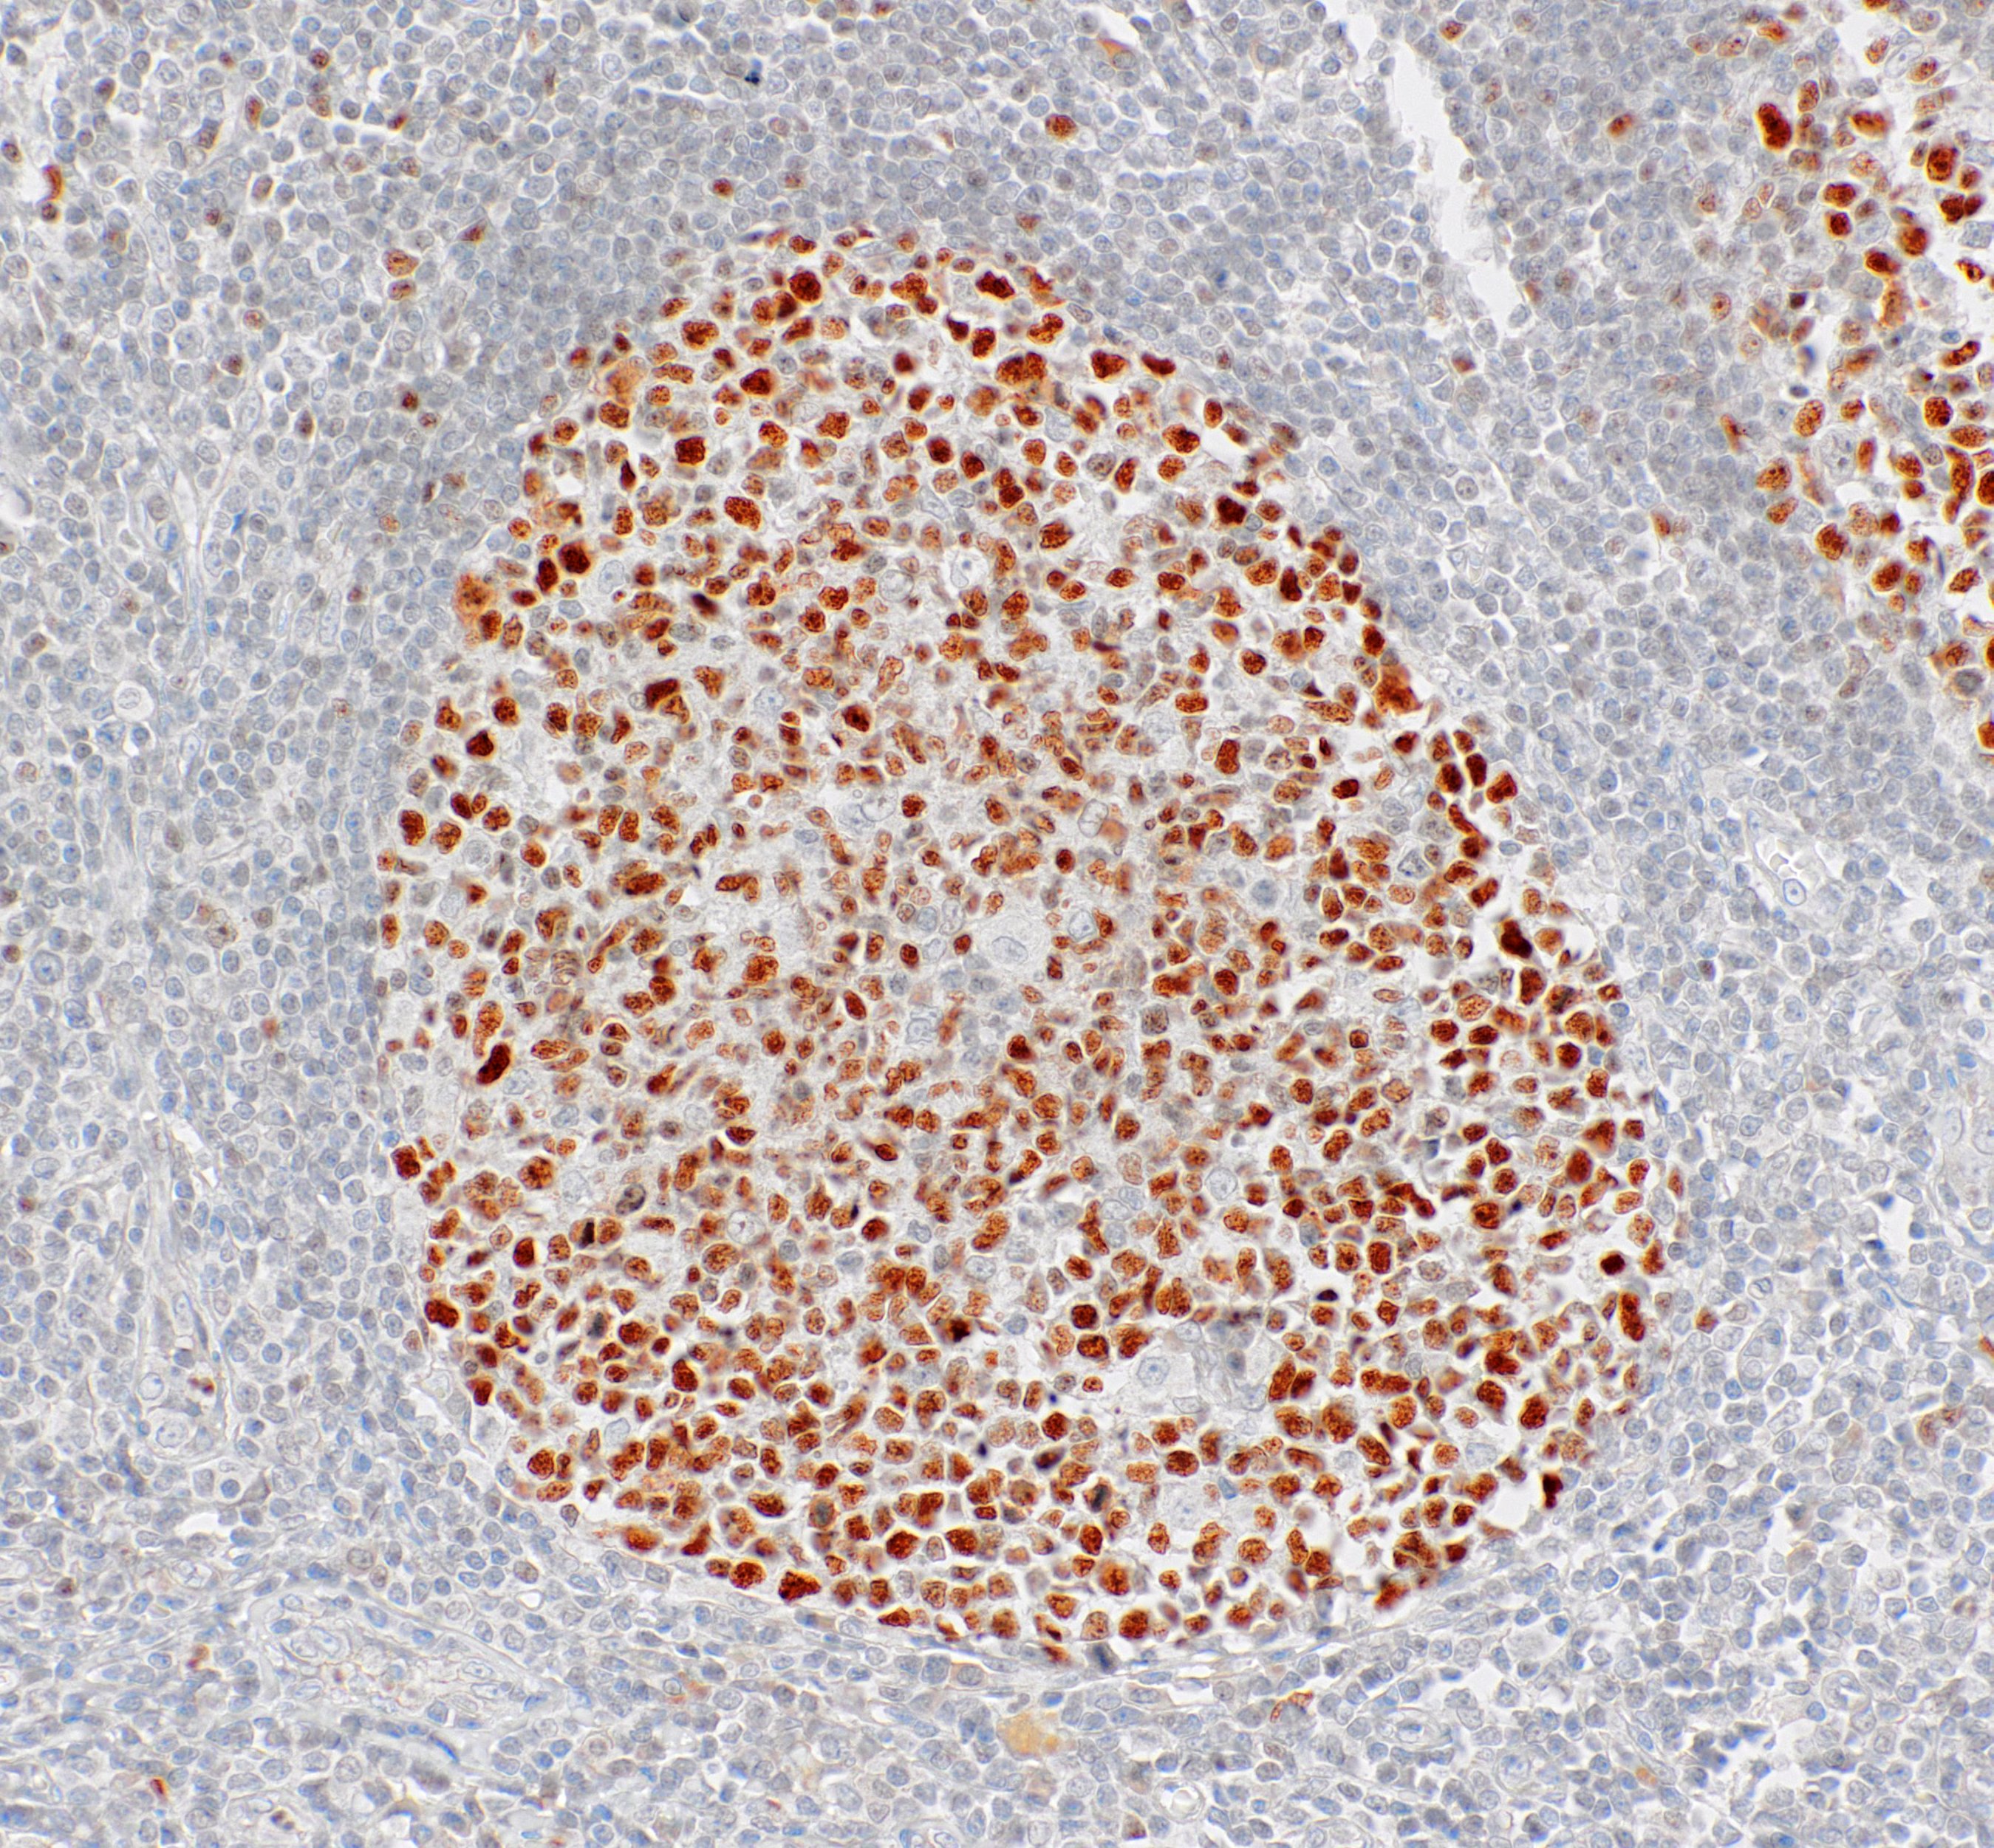

[Genomeme] BCL6
CAT. NO. IHC515-100
Description
B-Cell Lymphoma 6 (BCL6) is a zinc finger transcription factor. BCL6 expression is seen in follicular lymphomas, Burkitt's lymphoma, angioimmunoblastic T-cell lymphoma, and nodular lymphocyte-predominant Hodgkin's lymphoma. Together with BCL2, BCL6 is often used to distinguish neoplastic follicles from those in benign hyperplasia, and to aid in the classification of mantle cell lymphomas and nodular lymphocyte-predominant Hodgkin's lymphoma.
Documents
DATASHEETS
OTHERS
Specifications
CLONE:
IHC515
ISOTYPE:
IgG1
HOST SPECIES:
Mouse
CLONALITY:
Monoclonal
POSITIVE CONTROL:
Tonsil
DILUTION RANGE:
INTENDED USE/REG. STATUS:
CE-IVDSpecifications
CLONE:
IHC515
ISOTYPE:
IgG1
HOST SPECIES:
Mouse
CLONALITY:
Monoclonal
POSITIVE CONTROL:
Tonsil
DILUTION RANGE:
INTENDED USE/REG. STATUS:
CE-IVD
'Genomeme' 카테고리의 다른 글
| [Genomeme] B7-H4 (0) | 2021.12.22 |
|---|---|
| [Genomeme] CD23 (0) | 2021.09.24 |
| [Genomeme] Helicobacter pylori (0) | 2021.08.11 |
| [Genomeme] Annexin A1 (0) | 2021.07.08 |
| [Genomeme] CD57 (0) | 2021.06.09 |